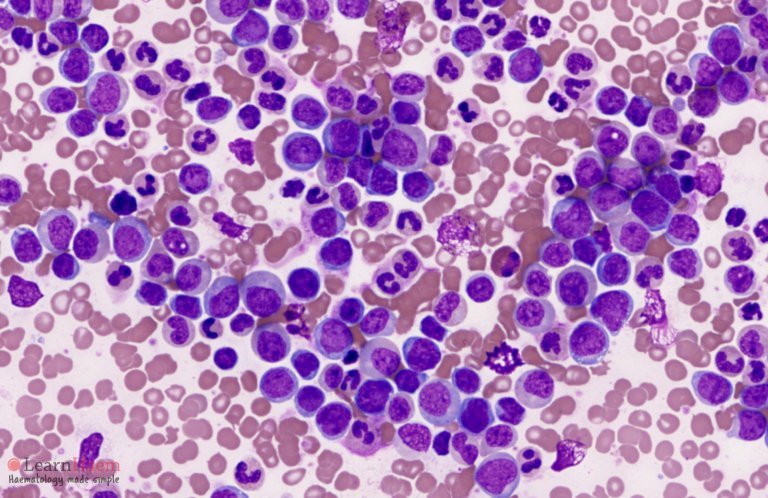

knightf3
@d4knightf3
mbbs'27
ID: 1619340363319369729
28-01-2023 14:23:43
105 Tweet
18 Takipçi
167 Takip Edilen



Keith Siau These are Mees’ lines (transverse leukonychia) 🔹occur when there is abnormal keratinization of the distal nail matrix & extends the complete width of the nail plate. 🔹 this patient likely had six chemotherapy cycles, which correspond each band of leukonychia.



Modern Health Barrett's esophagus is a condition in which there is an abnormal (metaplastic) change in the mucosal cells lining the lower portion of the esophagus, from stratified squamous epithelium to simple columnar epithelium with interspersed goblet cells that are normally present only in